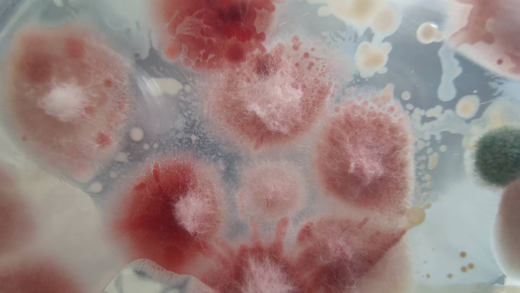
Diversidad genética y agresividad de Fusarium

Bienvenidos a nuestro espacio de conocimiento
En Germen, creemos en compartir conocimientos y soluciones innovadoras para mejorar cada aspecto de la agricultura. Este es tu lugar para descubrir artículos sobre restauración de suelos, biotecnología aplicada a cultivos, estrategias para un manejo más sostenible, cambio climático, precios del mercado agrícola y muchos otros temas.
Nuestro objetivo es ofrecerte información actualizada, relevante y práctica para que tomes decisiones informadas y lleves tus cultivos y proyectos al siguiente nivel. Este es tu espacio para explorar, aprender y crecer.
¡Te invitamos a descubrir todo lo que tenemos preparado para ti!
News
Diversidad genética y agresividad de Fusarium
🌧 Las lluvias están llegando y con ellas fitopatógenos como el micro hongo del género fusarium *Fusarium*, el terror de las cosechas, que afectan a un alto rango de especies de cultivo y que pueden resultar riesgosos para la salud humana.
El Fusarium es de gran importancia debido a su impacto negativo en los cultivos. Este género de hongos patógenos causa enfermedades graves en las plantas, debilitándolas e incluso llevándolas a la muerte. Además, algunas especies de Fusarium producen toxinas perjudiciales para la salud. Esto significa que afecta tanto la producción agrícola como la seguridad alimentaria. Es fundamental implementar medidas de prevención y control para proteger los cultivos y evitar pérdidas económicas significativas. El manejo adecuado del Fusarium implica la adopción de prácticas agrícolas adecuadas y el uso de variedades resistentes, fungicidas y técnicas de manejo integrado de plagas. De esta manera, se garantiza la salud de los cultivos y se preserva la seguridad alimentaria de la población.
En este Newsletter Germen Biotecnología te explicamos qué es el Fusarium, sus características y la importancia de conocer la diversidad genética de este microorganismo. 🦠🦠🥀🥀
¿Sabías que la ola de calor que nos está golpeando no es una ola de calor común sino un domo de calor? 🔥🌡️☀️
En este Newsletter descubre de qué se trata este fenómeno, por qué se presenta y como las poblaciones de este lado del globo se han visto afectadas por este fenómeno. Así como los pronósticos que se esperan para las condiciones climatológicas del país. No te pierdas de esta entrega del Newsletter de Germen Biotec y conoce la razón de nuestra condición climática más actual.
💡 ¿Está peleado el uso de plaguicidas con los bioestimulantes?
Descubre el equilibrio perfecto para proteger los cultivos y el medio ambiente. Utiliza pesticidas de manera responsable y explora el poder de los bioestimulantes.
La FAO nos guía hacia las buenas prácticas agrícolas, donde el monitoreo constante y la elección adecuada de pesticidas son fundamentales. Sin embargo, también es crucial capacitar a los agricultores en el uso seguro de estos productos y promover alternativas no químicas cuando sea posible.
Aquí es donde los bioestimulantes brillan. Elaborados con componentes orgánicos y naturales, fortalecen las plantas, mejoran la absorción de nutrientes y estimulan microorganismos benéficos en el suelo. Esto no solo aumenta la productividad agrícola, sino que también reduce la dependencia de pesticidas químicos.
La combinación estratégica de pesticidas y bioestimulantes ofrece resultados sinérgicos poderosos. Al integrar prácticas de manejo de plagas y utilizar responsablemente los pesticidas, logramos una agricultura más sostenible y segura.
¡Protege tus cultivos y el futuro de la alimentación! Adopta un enfoque integrado, donde la sinergia entre pesticidas y bioestimulantes nos lleve hacia una agricultura equilibrada y respetuosa con el medio ambiente. 🌎
Efectos de los plaguicidas en la salud: Qué le hacen al cuerpo y por qué son peligrosos?
🌐🌲 Protege tu salud y el medio ambiente: adopta prácticas agrícolas seguras y sostenibles.
⚠ En la industria agrícola, el uso indiscriminado de pesticidas representa una preocupación creciente debido a sus impactos negativos en la salud humana y el ecosistema. Los pesticidas tóxicos pueden dejar residuos dañinos en los alimentos que consumimos y contaminar los recursos hídricos.
Es fundamental tomar medidas responsables y optar por métodos amigables con el ambiente para preservar nuestra salud y el equilibrio ecológico. Te invitamos a explorar alternativas seguras y sostenibles, y a unirte a nuestra comunidad comprometida con una agricultura responsable.
Suscribiéndote a nuestra página, encontrarás información especializada sobre los riesgos asociados al uso de pesticidas y descubrirás soluciones eficaces basadas en métodos ecológicos. Recibirás consejos prácticos, recursos técnicos y noticias relevantes sobre eventos y avances en el campo de la agricultura ecológica. 😀🍎🌎
❗ Tu elección es esencial para salvaguardar tu bienestar y el del medio ambiente. Al optar por prácticas agrícolas seguras y sostenibles, contribuyes a proteger la salud de tu familia, minimizar la exposición a sustancias tóxicas y preservar la biodiversidad y la calidad de nuestros recursos hídricos.
Únete a nosotros en este importante cambio. Suscríbete ahora y forma parte de una comunidad de profesionales comprometidos con la adopción de métodos agrícolas seguros y sostenibles. Juntos, podemos marcar la diferencia y construir un futuro donde la agricultura y la protección ambiental vayan de la mano.
No comprometas tu salud ni el equilibrio ecológico. Elige prácticas agrícolas profesionales y amigables con el medio ambiente. Suscríbete y descubre un mundo de conocimiento y oportunidades para cultivar de manera responsable. ¡Te damos la bienvenida a nuestro Newsletter! ❗❕😃
USO INDEBIDO DE PLAGU/CIDAS Y SUS CONCECUENCIAS: TOXICIDAD HUMANA Y VIDA DEL SUELO (ETAPA I)
⚠¿Sabes lo que sucede a fondo con los plaguicidas?
Los plaguicidas son algo muy común el día a día en el campo, pero ¿sabes el daño que provocan en el suelo y agua? y que son acarreados en alimentos poniendo en riesgo a nuestra salud? 💧🍓
Te invitamos a checar el nuevo Newsletter de Germen Biotecnología y entérate de las consecuencias que el uso excesivo de plaguicidas en campo genera en la población y el ambiente.
Escasez de mano de obra en campo: Un nuevo riesgo para la seguridad alimentaria
❗❗ ¿Te has preguntado por qué hay tanta falta de mano de obra en el campo? y ¿cuál es su motivo?
El campo está presentando un problema importante que es la escasez de mano de obra. Esto sucede por la falta de trabajadores y el desdén de los jóvenes en busca del sueño americano, lo que repercute en la industria alimentaria mexicana. 🥑
Este problema ha escalado a nivel global, presentándose en crisis de trabajadores en Europa y Asia, esto podría traer consecuencias futuras como una crisis alimentaria y económica.
Método de acción de probióticos en la rizosfera microbiana: Pseudomonas
Descubre como la actividad de las Pseudomonas ayudan a mantener el balance de la rizosfera y la relación entre plantas y bacterias del suelo. 🍃
En la actualidad, la agricultura ha ido remplazando los fertilizantes convencionales con los biofertilizantes a base de microorganismos del suelo, que ha ayudado al desarrollo y crecimiento de plantas más resistentes a la contaminación de factores bióticos y abióticos.
De los géneros más utilizados, hoy vamos a centrarnos en Pseudomonas. 🍄👩⚕️
PROBIÓTICOS y PREBIÓTICOS: su importancia en la agricultura
Cada vez se ven más implementados en la industria agricola los microorganismos benéficos como los hongos y bacterias para los cultivos. En este articulo te daremos a conocer a los prebioticos y probioticos, su importancia y uso en los suelos y en la agricultura.